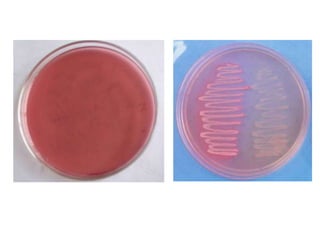
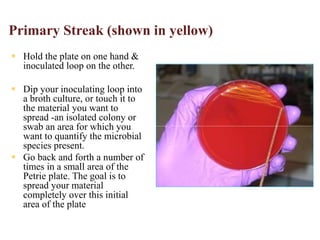
Primary Streak (shown in yellow)
 Hold the plate on one hand &
inoculated loop on the other.
 Dip your inoculating loop into
a broth culture, or touch it to
the material you want to
spread -an isolated colony or
swab an area for which you
want to quantify the microbial
species present.
 Go back and forth a number of
times in a small area of the
Petrie plate. The goal is to
spread your material
completely over this initial
area of the plate
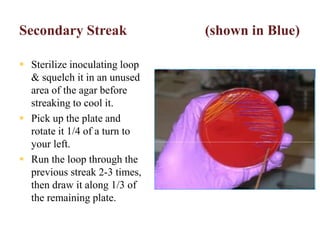
Secondary Streak (shown in Blue)
 Sterilize inoculating loop
& squelch it in an unused
area of the agar before
streaking to cool it.
 Pick up the plate and
rotate it 1/4 of a turn to
your left.
 Run the loop through the
previous streak 2-3 times,
then draw it along 1/3 of
the remaining plate.
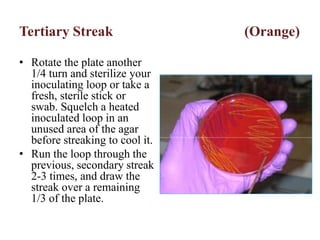
Tertiary Streak (Orange)
• Rotate the plate another
1/4 turn and sterilize your
inoculating loop or take a
fresh, sterile stick or
swab. Squelch a heated
inoculated loop in an
unused area of the agar
before streaking to cool it.
• Run the loop through the
previous, secondary streak
2-3 times, and draw the
streak over a remaining
1/3 of the plate.

Bacteria have either a gram-positive or gram-negative cell wall structure. Gram-positive bacteria have a thick peptidoglycan layer that retains crystal violet dye, while gram-negative bacteria have a thinner peptidoglycan layer and lipopolysaccharide outer membrane, causing them to take up the counterstain. Bacterial cell walls provide shape, protection from osmotic damage, and are the target of antibiotics.